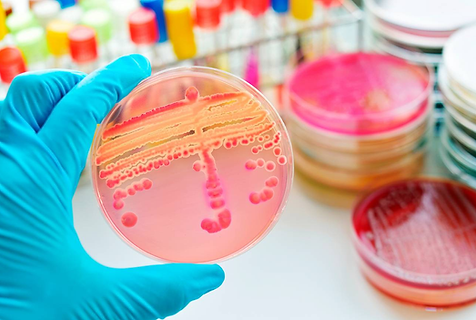
image.png

Alimentos
Análisis microbiológicos
​​
​Análisis bromatológicos
​​
Grasas y aceites, cenizas, proteínas, fibra cruda, carbohidratos y azucares​.​​

​​Análisis de agua embotellada
​
Este método consiste en una acidificación de la muestra de agua con ácido nítrico, seguida de una adsorción sobre carbón activado de los compuestos orgánicos contenidos en la muestra, para lo cual se utiliza una de las siguientes técnicas; agitación, cavitación o por adsorción en columna.​

​NOM-127-SSA1-1994 Salud ambiental, agua para uso y consumo humano
​​
Objetivo y campo de aplicación:
Esta Norma Oficial Mexicana establece los límites permisibles de calidad y los tratamientos de potabilización del agua para uso y consumo humano, que deben cumplir los sistemas de abastecimiento públicos y privados o cualquier persona física o moral que la distribuya, en todo el territorio nacional.​​
​​​​

​​​​NOM-201-SSA1-2015 Agua e hielo para consumo humano, envasados y a granel.​
​
Objetivo y campo de aplicación
​
Esta Norma establece las características y especificaciones sanitarias que deben cumplir el agua y el hielo para consumo humano que se comercialice preenvasado o a granel y los establecimientos que se dediquen al proceso o importación de dichos productos.
Esta Norma es de observancia obligatoria en el territorio nacional para las personas físicas o morales que se dedican al proceso o importación de agua y hielo para consumo humano que se comercialicen preenvasados o a granel. ​​

​Análisis de hielo
​
La cuenta heterotrófica en placa, formalmente conocida como cuenta estándar, es un producto de la estimación del No. de bacterias heterotróficas vivas, cuyo objetivo es determinar la efectividad de tratamiento y distribución del agua o hielo. Las colonias de bacterias pueden estar formadas por células agrupadas en pares, cadenas, racimos o separadas; todas ellas se incluyen en el término UFC. Su cuenta final dependerá de la interacción entre los microorganismos, el medio de cultivo elegido y el tiempo de incubación. Los métodos más comunes son: Vaciado en placa, filtración por membrana y extensión en placa. Se deben aplicar y controlar las condiciones en que se llevan a cabo estos métodos. ​

